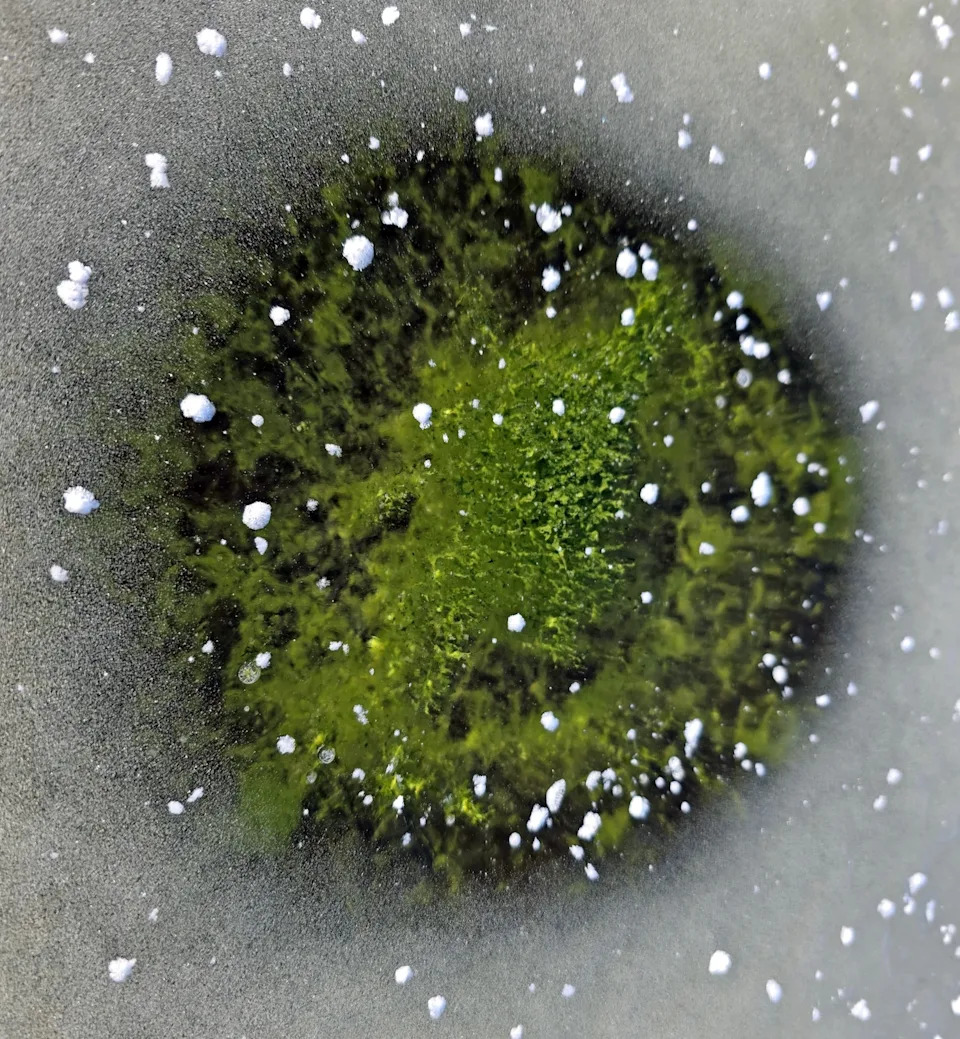
Emerald Ice: Toxic Cyanobacteria Bloom Persists Under Lake Lipno’s Winter Surface

At the end of 2025, researchers found a rare cyanobacterial bloom trapped beneath Lake Lipno’s newly formed ice, turning portions of the surface emerald green. Samples identified the species as Woronichinia naegeliana, with a brief melt-refreeze around December 24 forming distinct "cyanobacterial eyes." The bloom only faded after heavy snowfall blocked sunlight. Scientists warn that eutrophication and climate change could make winter blooms more common, raising ecological and public-health concerns.
Emerald Ice: Toxic Cyanobacteria Bloom Persists Under Lake Lipno’s Winter Surface

Biologists from the Czech Academy of Sciences were given a rare winter research opportunity when Lake Lipno’s ice turned an unmistakable emerald green at the end of 2025. The color came from a persistent cyanobacterial bloom trapped just below the newly formed ice, allowing scientists to collect and analyze live material in midwinter.
Lake Lipno is no stranger to cyanobacteria. These photosynthetic blue-green algae typically flourish in warm months when excess nutrients—especially phosphorus from agricultural and industrial runoff—create eutrophic conditions. While blooms often produce unpleasant odors, the greater danger is the cyanotoxins they release, which can accumulate in fish and other aquatic organisms and pose risks to humans and animals that contact or ingest contaminated water.

Unlike most Czech reservoirs where blooms fade by late September, Lake Lipno has a history of prolonged algal seasons extending into late autumn and occasionally winter. At the close of 2025, several weeks of strong sunshine, calm weather and light winds allowed algal biomass to remain concentrated at the surface as temperatures dropped and ice formed. Field samples confirmed the bloom was dominated by the common freshwater species Woronichinia naegeliana.
The thin new ice itself was clear, so the dense mats of cyanobacteria beneath retained their vivid green color and were visible from the shore and from overhead. A brief warm spell around December 24 caused partial melting followed by refreezing. Differences in solar heating and ice clarity produced patches of clearer ice over denser algal mats, creating striking features researchers dubbed "cyanobacterial eyes." The bloom persisted until heavy snowfall finally reduced light penetration enough to halt photosynthesis beneath the ice and cause the algae to dissipate.
Scientists are uncertain how repeated winter blooms will affect lake ecosystems over time, but they warn such events will likely become more frequent as climate change lengthens warm seasons and human activities continue to enrich waters with nutrients. Winter blooms could extend risks to aquatic life and human health beyond the traditional summer months, complicating monitoring and public-safety messaging.
“Green ice on Lake Lipno fits into the long-term changes we observe here in connection with eutrophication and ongoing climate change,” said hydrobiologist Petr Znachor. “It suggests that we may witness similar surprises more frequently in the future.”
Implications and Next Steps
Researchers recommend expanding year-round monitoring of vulnerable reservoirs, reducing phosphorus inputs from agriculture and industry, and improving public advisories about the risks of cyanotoxins even during cold months. Continued study of winter blooms will help managers anticipate ecological impacts and protect communities that rely on freshwater resources.
Help us improve.


































